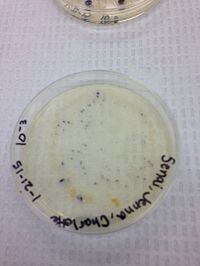
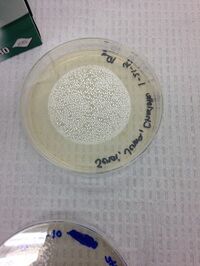
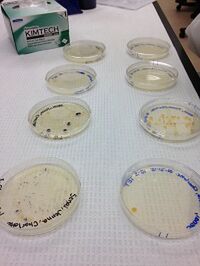

User:Leo Roisman/Notebook/Biology 210 at AU
Sunday, March 22, 2015
Zebrafish Results
Media:Roismanzebrafishresults.jpg
Wednesday, February 25, 2015
Microbiology Part 2: Bacterial DNA Sequencing
Purpose:
The purpose of this lab was to utilize PCR to isolate and identify DNA from bacterial spores present in our Hay Infusion, as well as to compare this data to our previous analysis of the same bacterial samples and to our background research about common bacteria that populate marshland ecology.
Materials and Methods:
We isolated two samples of bacterial cultures created from our Hay Infusion taken during Week 3's microbiology lab (which were later cultivated on agar and tetracycline plates for further testing). We then performed a PCR reaction to replicate the DNA of this bacterial colony so that it could be identified and tested. The testing itself was done by the lab director, but we were given a portion of the DNA sequence electronically via Genewiz, and then utilized the NIH's online Nucleotide BLAST program to identify the gene from which the DNA sequence originated. We then recorded the accession number of the highest percent match listed on the BLAST output, and identified the organism that contained this DNA sequence. We repeated this procedure for our second sample, and finally, we researched the organism online in lab and compared our PCR identification to our previous identification of the bacterial colonies using microscopy.
Data and observations:
DNA sequence 21: (text file linked for brevity) Media:Roisman21.txt
Accession #: KM253193.1
Name: Pseudomonas
More Info: partial sequence from ribosomal RNA gene; sp. ST 6-02 16S
DNA sequence 22: Media:Roisman22.txt
Accession # : KP410018.1
Name: Uncultured prokaryote clone
More Info: partial sequence from ribosomal RNA gene; seq_H09_Z118570_Z079336a_W-X9_16SR 16S
Conclusions:
We found that the bacterial spores in question were both ribosomal RNA samples from pseudomonas and an unnamed prokaryote. This confirmed our previous results in our studies of the bacteria's colony morphology, motility, and gram staining, in that we confirmed the presence of pseudomonas in our primary colony, which we identified under a microscope, and confirmed that it was gram negative, in accordance with our previous results.
References:
"Basic Local Alignment Search Tool." National Center for Biotechnology Information. National Institutes of Health. Web. 3 Mar. 2015. <http://blast.ncbi.nlm.nih.gov/blast/Blast.cgi?PROGRAM=blastn&PAGE_TYPE=BlastSearch&LINK_LOC=blasthome>.
Bentley, Meg, et al. 2015. A Laboratory Manual to Accompany: General Biology II. Department of Biology, American University.
Freeman, Scott. 2014. Biological Science. Prentice Hall: New Jersey.
"Order Results." GENEWIZ Online System. Genewiz LLC. Web. 3 Mar. 2015. <https://clims3.genewiz.com/>.
Wednesday, February 11, 2015
Lab 5: Invertebrates
Purpose:
The purpose of this lab is to identify invertebrates found in our marsh transect using the Berlese funnel, and more broadly, to learn how simple systems evolved into more complex systems and to understand the ecological importance of invertebrates.
Materials and Methods:
Our procedure had three parts. First, we observed prepared slides of Planaria, nematodes, and Annelida using a microscope in lab. Second, we observed pre-preserved specimens of the five major classes of arthropods: arachnida, diplopoda, chilopoda, and crustacea. Third, we took samples of invertebrates collected using our Berlese funnel, and we observed them under a microscope; we then used a dichotomous key to identify the organisms we found. Finally, we used the Freeman textbook to analyze categories of vertebrates and analyze them in relation to our data.
Data and observations:
Procedure 1:
Figure 1: Planaria
We observed a ~2mm oval cross section of this worm, as it digested some egg yolk. We found an ectoderm, a mesoderm, and an endoderm. While the membrane contained all three layers, this worm had the simplest internal structure of the three observed, and thus presumably requires less complex movement.
Figure 2: Nematodes
We observed a round 0.5 mm cross section of this worm, and found an ectoderm, 2 endoderms, 2 mesoderms, and a clear cavity.
Figure 3: Annelida
We observed a round 0.125 mm cross section of this worm, and found 2 ectoderms and 2 mesoderms, as well as a clear cavity. We observed its digestive system to be central to its cross-section, with muscle wrapped around it.
Procedure 3:
The size range of organisms was 2.0 to 50.0 mm. The largest organism was the termite (Arthropoda Insecta), while the smallest was the Striped Springtail (Arthropoda Collembola). The most common type of organisms in leaf litter was also the termite (Arthropoda Insecta).
Figure 4:Isopoda
This image is a close-up of our Isopoda (Arthropoda Malacostraca) under the microscope.
Five vertebrates that might inhabit the transect are the crow, raccoon, squirrel, sparrow, and lizard, as described in Table 2 below:
The food web corresponding to these vertebrates can be seen in Figure 5, below:
Conclusions:
In conclusion, these organisms represent the ecological concept of community in that they comprise the living component of the ecosystem in this specific geographic area. The carrying capacity of this region is the number of organisms from a species that can live in this specific ecological niche, and the fact that the transect can support a given number of each of these vertebrates represents that the carrying capacity of the niche allows for these populations. The trophic levels, as described in the food web above, represent the way in which various species interact with each other as producers and consumers of food; i.e. primary, secondary, or tertiary; the vertebrates discussed are all at higher trophic levels, because they consume food but do not produce food that most other organisms in the transect readily consume.
References:
Bentley, Meg, et al. 2015. A Laboratory Manual to Accompany: General Biology II. Department of Biology, American University. 44-49.
Freeman, Scott. 2014. Biological Science. Prentice Hall: New Jersey. 1150-1154.
Lab 3: Microbiology and Antibacterial Resistance
Purpose:
The purpose of this lab is to observe the differences in bacterial growth of serially diluted samples taken from our transect of marshland on American University's campus when introduced into two different environments, the first containing nutrients on an agar plate, and the second containing nutrients and the antibiotic tetracycline on an agar plate. The goal was to observe colony size, shape, color, and number, and observe the differences among the plates to draw conclusions about the effect of tetracycline on bacterial growth.
Materials and Methods:
We used samples of our three-week-old Hay infusion from our marshland transect in order to find bacteria to observe. We then serially diluted these bacterial samples to 10^-3, 10^-5, 10^-7, and 10^-9 in order to more clearly compare the effects of the different environments on bacterial concentration. We placed one sample from each dilution onto both a nutrient agar plate and a nutrient + tetracycline agar plate, for a total of eight bacterial plates. We then created wet mounts using two of our samples (10^-5 nutrient plate and 10^-5 nutrient+tetracycline plate) in order to observe the motility and type of bacteria present. Additionally, we conducted gram tests in which we exposed these same bacterial samples to crystal violet die, iodine mordant, alcohol, and safranin stain, before flushing the samples with water, in order to observe if dye remained and therefore if the samples were gram positive or negative. Finally, we prepared a PCR sample of the same bacterial samples for next week's lab by transferring the samples into tubes of water, incubating them to encourage growth, centrifuging to separate out the supernatant, and collecting samples of the remaining bacteria with which to perform a PCR reaction in the next lab.
Data and Observations:
1. I hypothesize that Achaea will not have grown on the agar plates, because our Hay infusion was not taken from an extreme environment, but rather from marshland.
2. The Hay infusion is an odorless and colorless liquid, whereas last week, it was pungent and more viscous, and the dirt was suspended throughout the substance rather than settled at the bottom, which it currently is. I hypothesize that some of the bacteria died off due to the change in environment, as well as potentially eating through all of the nutrients from the powdered milk initially added to the Hay infusion, such that the current sample is potentially less able to sustain life.
3. The colonies on the plates without antibiotics are more numerous and are different colors; in fact, only the 10^-5 tetracycline sample grew visible colonies of bacteria. This indicates that the tetracycline killed all of the other bacteria but one, because this species is resistant to tetracycline.
4. The four colonies we took samples from were from the 10^-3, 10^-5, and 10^-7 nutrient plates and the 10^-5 nutrient + tetracycline plates.

Conclusions:
In conclusion, tetracycline definitely had a discernible effect on bacterial growth and colony size, although one of our bacterial samples (which we hypothesized to be []) was tetracycline resistant, while all of the observed bacteria was gram positive.
References:
Bentley, Meg, et al. 2015. A Laboratory Manual to Accompany: General Biology II. Department of Biology, American University. 25-32.
Lab 2:Identifying Algae and Protists
Purpose:
The purpose of this lab was to practice using a dichotomous key to identify unknown organisms, as well as to understand the characteristics of algae and protists, both generally and within our transect.
Materials and Methods:
In this lab, we used a dichotomous key in order to identify organisms found in our Hay infusions, which we created last week. We then prepared serial dilutions of bacterial samples, using a micropipettor to add bacteria to 10 mL of a sterile broth. We then diluted this sample to 10^-2, 10^-4, 10^-6, and 10^-8, and added 100 microliters of each broth to both nutrient and nutrient + tetracycline agar plates. One set of agar plates, the control, simply contained nutrients for the bacteria to feed off of, while the second set also contained tetracycline, an antibiotic. In total, we created 8 different plates, which we set aside to grow for one week, in order to observe the bacterial colonies that will grow by next lab.
Data and Observation:
The Hay infusion contains brown muddy water, surface gel growth, and a pungent smell. There are no molds or green shoots on top of the liquid, but there is a cloudy gel-like substance which may consist of a bacterial lawn.
Figure 1: Observation of plant matter from side of Hay infusion
In this sample, we found the following bacteria:
Colipidium (50 micrometers)
Didinium cyst (20 micrometers)
Bursaria truncatella (700 micrometers)
Figure 2: Observation of liquid/gel from aerial view of Hay infusion
In this sample, we found the following bacteria:
Spirostomum (1 millimiter)
Paramecium aureli (120 micrometers)
Chlamydomonas (10 micrometers)
Conclusions:
The chlamydomonoas species, as well as all of the species of bacteria observed, meets all of the needs of life as described on page 2 of the Freeman text in that is made of cells--which we observed in class--transfers information, consumes and uses energy, and evolves.
If the Hay Infusion Culture grew for another two months, I would expect that the jar would be overtaken by visible bacteria, mold, and fungi. I suspect that some bacterial colonies would die off, either through being consumed by other organisms or by being unable to adapt to the new environment. The selective pressures affecting the community of the sample is a limited amount of oxygen and carbon dioxyde circulation--because the lid is closed, the ecosystem within must maintain a balance of each in order for the plants or organisms inside to respirate properly. Additionally, the plants will break down regardless due to a lack of sunlight, and will probably be eaten by bacteria, but there is also a limited amount of nutrients (provided by both plant matter and the powdered milk), so eventually, organisms may begin to die due to lack of food.
References:
Bentley, Meg, et al. 2015. A Laboratory Manual to Accompany: General Biology II. Department of Biology, American University. 18-24.
Lab 1: Biological Life at AU
Purpose:
The purpose of this experiment is to understand how the evolution of different species may be affected by natural selection, as well as to observe the characteristics of a given transect of land on AU's campus.
Materials and Methods:
In this experiment, we first observed the evolutionary specialization of members of the Volvocine line using wet mounts of chlamydomonoas, gonium, and volvox bacteria which were provided for us in the laboratory. Then, we observed our transect outdoors on AU's quad and collected samples of plant life and soil in a tube, being careful to include samples of all biotic features. We then returned to the lab and created a Hay infusion from this sample by the sample, along with powdered milk and water, to a jar, which we allowed to sit for three weeks such that some of the bacteria present in the transect would grow while isolated in the jar, to be observed at a later date.
Data and Observation:
This transect of manicured grassland is located in the quad in front of Hurst Hall on the American University campus. An aerial map of the campus can be viewed below, with abiotic and biotic components listed.
Biotic features: leaves; rose bushes; weeds; grass; sticks; and woodchips.
Abiotic features: snow; concrete (path and statue); dirt; rocks; water; and refuse (plastic forks).
Figure 1: Aerial view of transect with listed features
Conclusions:
Notable effects on the transect's bacterial life, which are to be observed in the following experiment, may occur from the shade from nearby trees, falling leaves, and human traffic across campus. However, the Hay infusion collected contained a rich sample of various types of plant matter and soil, and therefore it is likely that an abundance and variety of bacteria will be able to be observed.
References:
Bentley, Meg, et al. 2015. A Laboratory Manual to Accompany: General Biology II. Department of Biology, American University. 12-17.












